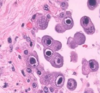
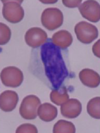

PHD - Human Herpesviruses (Kasman) Flashcards
(63 cards)
A 28-year-old letter carrier presents with painful recurring vesicular eruption on the lip. Which of the following would you expect to see in a smear from the base of a vesicle? Select all that apply.
A. Cowdrey Bodies
B. Downey Cells
C. Heterophile antibodies
D. Owl’s eye cells
E. Tzank Cells
Cowdrey bodies and Tzank Cells (A and E)
Patient presentation indicates that he has HHV-1 because of the recurring vesicular “cold sore” on the lip.
Downey cells are manifestations of CMV and EBV
Heterophile antibodies indicate primary infection with EBV (mononucleosis)
Owl’s eye cells are indicative of CMV (Remember, you “C” with your eyes)
A 16-year-old high school student has been ill with fever, fatigue, pharyngitis, and swollen cervical lymph nodes. Physical examination reveals an enlarged spleen. A blood sample is obtained. Which of the following would you expect to see in a CBC with differential analysis of peripheral leukocytes?
A. High eosinophil count
B. High monocyte count
C. High lymphocyte count
D. High neutrophil count with bands
E. Multinucleated giant cells
C. High lymphocyte count
This question stem is describing EBV with infectious mononucleosis. Remember that this causes a proliferation of B-cells and CD8+ T-cells in the lymph nodes, leading to enlarged nodes.
A 16-year-old high school student has been ill with fever, fatigue, pharyngitis and swollen cervical lymph nodes for 2 weeks. Physical examination reveals an enlarged spleen. A heterophile antibody test is positive. What is another disease caused by this virus?
A. Burkitt Lymphoma
B. Herpes encephalitis
C. Herpetic whitlow
D. Multicentric Castleman’s Disease
E. Viral retinitis
A. Burkitt Lymphoma
EBV is a gamma-herpesvirus, meaning that it can lead to formation of tumors, in particular Burkitt Lymphoma.
B and C are incorrect because these are caused by HHV-1 and 2 (alpha-herpesviruses)
D is caused by HHV-8 (Kaposi)
E is caused by CMV
A 53-year-old lawyer is recovering from a kidney transplant 2 months prior when she develops viral pneumonia, fever, and signs of graft failure. Diagnostic tests are positive for herpesvirus. Which of the following is the most likely type of herpesvirus?
A. CMV
B. EBV
C. HHV-6 (Roseola)
D. HSV-1
E. KHSV (HHV-8)
A. CMV
Beta-herpesviruses (CMV, HHV-6 and 7) are typically associated with development of infections in immune compromised patients.
EBV is associated with Burkitt Lymphoma
C would be correct if the patient were between ages 4 and 6 (almost exclusively in kids)
D is associated with Herpes simplex encephalitis
E is associated with Kaposi Sarcoma
What herpesvirus induces the formation of Multicentric Castleman’s disease?
HHV-8
What is the enzyme that activates acyclovir from its prodrug to drug form?
Thymidine kinase
Roseola infantum is a condition caused by what herpesvirus?
HHV-6 and HHV-7
HHV-6 and HHV-7 primarily infect what cell type?
T-cells
What is the Tzanck smear used to diagnose?
HHV-1, 2, and 3

Which herpes virus can affect both, T and B lymphocytes?
Cytomegalovirus (HHV-4)
CMV starts by infecting epithelial cells, but then moves into the B-cells to replicate.
CD8+ T-cells become involved with infectious mononucleosis
IgM against early antigens (EA) or viral capsid antigen (VCA) is indicative of what?
Primary EBV infection
IgM against EBV-nuclear antigens (EBNA) also indicates EBV infection
CMV has what characteristic histological appearence?
Owl’s eyes nuclear inclusions
Remember: you “C” with your eyes, so CMV is indicated by owl’s eyes
Owl’s eyes are inclusion bodies surrounded by a halo in CMV infected cells.
What drugs are oftentimes prodrugs which need to be metabolically activated through phosphrylation to prevent viral DNA polymerase activation and promotes chain termination?
Cyclovir drugs
(Acyclovir, valacyclovir, gancyclovir, valagancyclovir)
These drugs have a preference for being activated in virally infected cells. The enzyme thymidine kinase expressed in virally-infected cells converts cyclovir drugs to the active form.
The histological sample below is indicavtive of what infection?

CMV
The histological slide shows Owl’s eye inclusions, which are indicative of CMV-infected cells.
What drug can be used to treat herpes encephalitis?
Acyclovir
Herpes encephalitis is a consequence of HHV-1 infection that causes unilateral lytic lesions of the temporoparietal brain
What age is primarily affected by HHV6 and HHV7?
6 months to 4 years old
Roseola infection is almost exclusively limited to this age range.
In what age group is HSV1 and 2 fatal?
Neonates
What is this condition and which pathogen causes it?

Kaposi Sarcoma caused by EBV
EBV is one of the gamma-herpesviruses. These viruses are tumorigenic. EBV infection is associated with development of Kaposi Sarcoma, which is characterized by dark lesions caused by infiltration of tissue with blood.
Which herpesvirus induces retinits, and has mononucleosis-like symptoms?
CMV
Treat with gancyclovir
Which herpes virus almost always features symptoms?
Varicella-Zoster (HHV-3)
HHV-3 is the only herpesvirus that almost always features symptoms. The other herpesviruses tend to remain asymptomatic and rarely cause any sumptoms.
Explain how guanine analogs have low-toxicity and are specific to infected cells.
Guanine analogs are pro-drugs, so they don’t readily affect cells, making them less toxic.
These drugs require activation via the enzyme thymidine kinase. Virally-infected cells tend to have high levels of this enzyme, which makes these drugs more likely to work in infected cells.
What is herpes keratitis?
Herpes infection of the eye.
Typically seen in HHV-1 and 2
A 20 month old child presents with a high fever and seizures. 4 days later the fever breaks, and he develops a pink macular rash. What condition is this? And what test should be requested to confirm the diagnosis?

Roseola infantum (HHV-6 and 7)
Diagnosis of roseola is done by seroconversion. This is possible becasue this infection is lifelong and will always be present regardless of whether or not symptoms occur.
Typical Roseola patient: young child who started with fever that progressed to pink skin rash
What is herpetic whitlow?
Herpes vesicle of the cuticle
This is a common finding in dental workers and is caused by HHV-1 and 2.